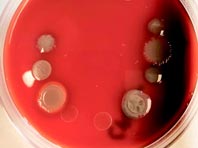

Раскрыта неожиданная опасность зубной пасты
Раскрыта неожиданная опасность зубной пасты Вещество снижает иммунитет и уменьшает количество полезных микроорганизмов в кишечнике. Ученые из Франции рассказали о неожиданной опасности зубной пасты. В ней нашли вещество, которое оказалось страшным ядом, разъедающим эмаль зубов. По словам специалистов, они раскрыли «обман века». В зубной пасте содержится краситель под названием «диоксид титана». Его добавляют для того,…